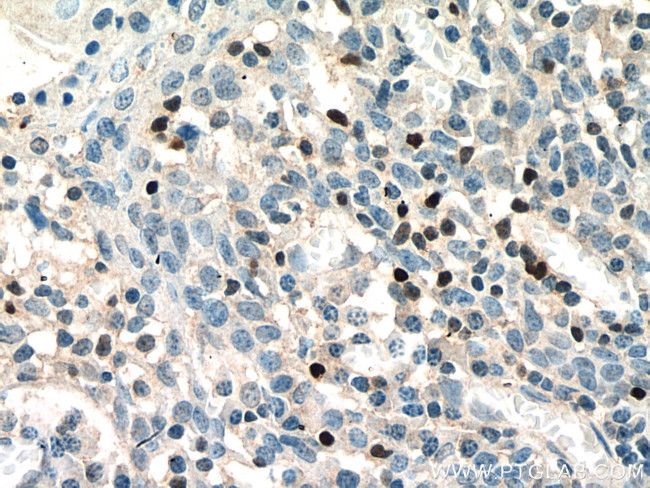
TBX21/T-bet Antibody in Immunohistochemistry (Paraffin) (IHC (P))

Search
Proteintech
TBX21/T-bet Polyclonal Antibody
{{$productOrderCtrl.translations['antibody.pdp.commerceCard.promotion.promotions']}}
{{$productOrderCtrl.translations['antibody.pdp.commerceCard.promotion.viewpromo']}}
{{$productOrderCtrl.translations['antibody.pdp.commerceCard.promotion.promocode']}}: {{promo.promoCode}} {{promo.promoTitle}} {{promo.promoDescription}}. {{$productOrderCtrl.translations['antibody.pdp.commerceCard.promotion.learnmore']}}
产品信息
13700-1-AP
种属反应
已发表种属
宿主/亚型
分类
类型
抗原
偶联物
形式
浓度
规格
纯化类型
保存液
内含物
保存条件
运输条件
产品详细信息
Immunogen sequence: MGIVEPGCG DMLTGTEPMP GSDEGRAPGA DPQHRYFYPE PGAQDADERR GGGSLGSPYP GGALVPAPPS RFLGAYAYPP RPQAAGFPGA GESFPPPADA EGYQPGEGYA APDPRAGLYP GPREDYALPA GLEVSGKLRV ALNNHLLWSK FNQHQTEMII TKQGRRMFPF LSFTVAGLEP TSHYRMFVDV VLVDQHHWRY QSGKWVQCGK AEGSMPGNRL YVHPDSPNTG AHWMRQEVSF GKLKLTNNKG ASNNVTQMIV LQSLHKYQPR LHIVEVNDGE PEAACNASNT HIFTFQETQF IAVTAYQNAE ITQLKIDNNP FAKGFRENF (1-328 aa encoded by BC039739 )
靶标信息
T-bet, also known as TBX21, is a T-cell specific transcription factor containing a single T-box DNA-binding domain. It controls the expression of the TH1 cytokine, interferon-gamma. Both Th1 and Th17 cells are crucial in immune regulation and autoimmune disease development. T-bet initiates Th1 lineage development from naive Th precursor cells and directs T cell differentiation to Th1 versus Th17. T-bet is cooperating with Stat4 (signal tranducer and activator of transcription 4) in programming chromatin architecture for Th1 gene expression. Genetic variations in T-bet are associated with susceptibility to aspirin-induced asthma and nasal polyps.
仅用于科研。不用于诊断过程。未经明确授权不得转售。
生物信息学
蛋白别名: HGNC:11599; T-box 21; T-box expressed in T cells; T-box protein 21; T-box transcription factor expressed in T cells; T-box transcription factor TBX21; T-cell-specific T-box transcription factor T-bet; Transcription factor TBLYM
基因别名: IMD88; T-bet; T-PET; TBET; TBLYM; TBT1; TBX21
UniProt ID: (Human) Q9UL17, (Mouse) Q9JKD8
Entrez Gene ID: (Human) 30009, (Mouse) 57765